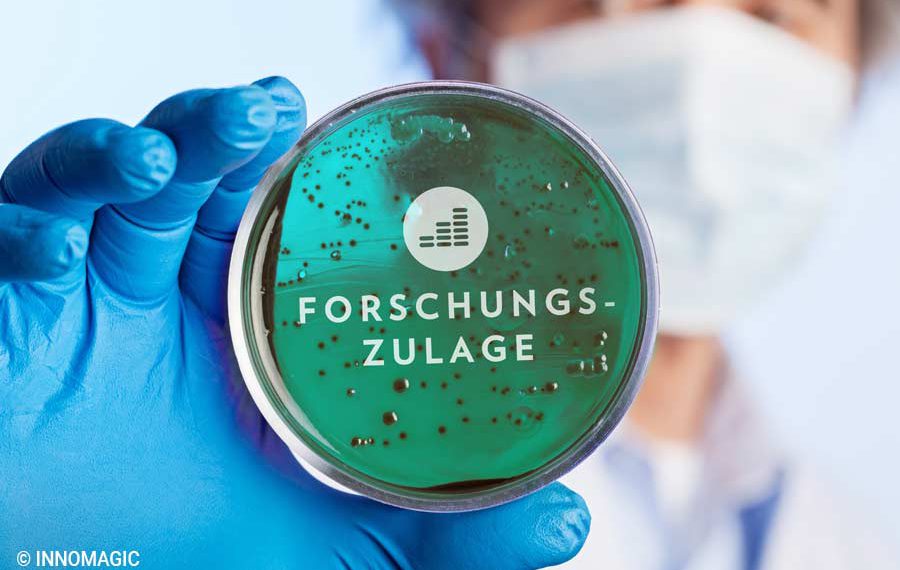

Nach knapp 1,5 Jahre Forschungszulage lud der Bund der Deutschen Industrie (BDI) am 6. Mai 2021 zum Expertengespräch über die Forschungszulage ein. Ins Gespräch kamen Dr. Ulrike Schramm, Global Head of Tax bei der Continental AG, Dr. Heike Balzer, Senior Vice President Finance Noxxon Pharma AG und Leiterin der Arbeitsgruppe Finanzen und Steuern bei BIO Deutschland e.V., Dr. Nils Weith vom Bundesministerium für Wirtschaft und Energie sowie Dipl.-Volkswirt Ulrich Meißner, Steuerexperte beim Verband Deutscher Maschinen- und Anlagenbau (VDMA). Das Gespräch in der BDI-Reihe Digital Deep Dive: Raus aus der Krise mit einem modernen Unternehmensteuerrecht (Teil 3), führte Cedric von der Hellen, Stellv. Abteilungsleiter Steuern und Finanzpolitik beim BDI.
Frau Dr. Schramm und Frau Dr. Balzer gaben ein erstes Feedback zur Forschungszulage aus ihren Branchen. Beide berichten, dass die Forschungszulage durchaus einen Motivationsschub ausgelöst hat.
„Obwohl die Beträge (Bemessungsgrundlage von 4 Millionen Euro) bei uns sehr gering sind und in der Großindustrie jetzt nicht neue Investitionsprojekte oder neue FuE-Investitionen damit angeschoben werden, aber es ist eine Anreizwirkung da“.- Frau Dr. Schramm
- Die Forschungszulage stellt eine zusätzliche Finanzierungsquelle dar.
- Es können neue Projekte in Angriff genommen werden, für die die Finanzierung bisher nicht zur Verfügung stand.
- Es gibt ein größeres Interesse an neuen Vorhaben.
- Durch die Forschungszulage ist es möglich, bestehende Personalressourcen mit dem entsprechenden Know-how auszulasten und halten zu können – gerade in schwierigen wirtschaftlichen Situationen.
- Beantragung ist trotz zweistufigen Verfahren wenig komplex.
- Die Dokumentation bindet relativ wenige Ressourcen.
Hinsichtlich der Dokumentation und des administrativen Aufwands gehen jedoch die Erfahrungen dahingehend auseinander, dass Frau Dr. Schramm für den Großkonzern Continental AG konstatiert: „Der administrative Aufwand ist höher als ursprünglich gedacht“. Und weiter sagt sie: „Gerade in einem Großunternehmen ist es so, dass sie nicht eine Person haben, die alles weiß, was in diesem Antrag reingeschrieben werde muss, sondern die Themen müssen sie sich beim Controlling, bei den Rechtskollegen und bei den Forschern selber einholen und das dauert mitunter relativ lange“. Ebenfalls als noch unbefriedigend aus der direkten Praxis schildert sie, dass die Antragsformulare nicht ohne Registrierung eingesehen werden können. Dies verzögert die Antragsstellung und sei eine unnötige Hürde. Umständlich für ein Großkonzern sei ebenfalls, dass alle verbundenen Unternehmen mit Namen, Steuernummer etc. eingetragen werden müssen – kein Upload eines Org-Charts möglich –, die in den Berechtigungskreis des Konzernverbundes in Betracht kommen.
Es gab auch Kritik. Frau Dr. Schramm als auch Frau Dr. Balzer sowie Herr Meißner äußerten Kritik an der Höhe der Forschungszulage: Fördersatz und Bemessungsgrundlage. Der steuerliche Erstattungsbetrag von 1 Million Euro pro Unternehmen pro Jahr sei für eine FZ-Beantragung als Konzernverbund nicht so hoch, so Frau Dr. Schramm. Für Herrn Meißner vom VDMA geht es ebenfalls um die Bemessungsgrundlage bzw. den Deckelbetrag. Generell konstatiert er, dass es für Maschinenbauunternehmen mit 1.000 bis 3.000 Mitarbeitern bislang kaum direkte Förderprogramme gibt.
Kritik kam auch an der Definition/Einordnung „verbundene Unternehmen“ und „Unternehmen in Schwierigkeiten“: Frau Dr. Balzer sagt über die aktuelle Definition zu verbundenen Unternehmen: „Das was hier das Hauptproblem darstellt ist, wenn Finanzierungen über Family Offices erfolgen und darüber ein Mehrheitsbesitz oder eine Mehrheit von beteiligten Unternehmen entsteht, dann eine Abstimmung nicht etwa in einem Konzernverbund notwendig wäre, sondern eine Abstimmung notwendig wäre zwischen Unternehmen die nur eine einzige Verbindung haben und das ist ihr Investor. Das ist etwas, was unseres Erachtens nach sehr intensiv diskutiert werden sollte und da brauchen wir unbedingt Abhilfe.“ „Ein zweites großes konzeptionelles Thema, was wir bitten in die Diskussion einzubringen, ist das Thema Unternehmen in Schwierigkeiten“, so Frau Dr. Balzer.
Dr. Niels Weith (BWMi) bestätigt, dass das Thema “verbundene Unternehmen” weiterentwickelt und auch ein Download der Antragsformulare möglich sein wird. Zudem berichtet Herr Meißner, dass die ersten Maschinenbau-Unternehmen bereits positive Bescheinigungen von der Bescheinigungsstelle Forschungszulage (BSFZ) erhalten haben. Diese Unternehmen können seit dem 1. April 2021 den Antrag auf Forschungszulage beim zuständigen Finanzamt einreichen. Einigkeit herrschte in der Gesprächsrunde darüber, dass die Forschungszulage ein wichtiges Anreizinstrument für Unternehmen ist, um in Forschung und Entwicklung zu investieren, wenngleich Anpassungen beim Fördersatz und der Bemessungsgrundlage notwendig sind.